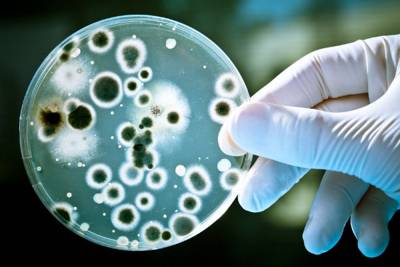
Гемолитический стрептококк в урологии

Как мы заболеваем
Люди заражаются стрептококковой инфекцией воздушно-капельным путем от больного носителя инфекции. Инфекция же мочевыводящей системы чаще всего является осложнением ангины, вызываемой бетта-гемолитическим стрептококком. Этот стрептококк поражает почечные клубочки (элемент почечного вещества, фильтрующий мочу) и вызвывает тяжелое заболевание гломерулонефрит.
Врачи подчеркивают, что гемолитический стрептококк, хотя и менее распространен в урологии, может вызывать серьезные осложнения. Инфекция, вызванная этим микроорганизмом, может приводить к развитию пиелонефрита и цистита, особенно у пациентов с ослабленным иммунитетом. Специалисты отмечают, что своевременная диагностика и лечение имеют решающее значение для предотвращения хронических заболеваний. Важно учитывать, что стрептококковая инфекция может маскироваться под другие урологические патологии, что затрудняет диагностику. Врачи рекомендуют регулярные обследования и внимательное отношение к симптомам, таким как боль при мочеиспускании и изменения в моче. Эффективное лечение включает антибиотикотерапию, однако выбор препарата должен основываться на результатах микробиологического анализа.

Стрептококковая инфекция
Есть такие основные группы стрептококков:
- альфа гемолитический стрептококк;
- бета гемолитический;
- негемолитический стрептококк.
Он может разрушать кровяные тельца, выделяя токсины в процессе своей жизнедеятельности. Этот яд способен негативно воздействовать практически на все органы. Об интоксикации будет свидетельствовать высокая температура, слабость, тошнота, боль.
Патогенные факторы стрептококка:
- способности нарушать целостность клеток крови;
- выделение токсинов – стрептолизина;
- разрушение иммунных клеток;
- способность омертвлять клетки;
- наличие ферментов, которые способствуют распространению бактерий в организме.
В области проникновения стрептококка развивается воспаление. Человека беспокоит сильная боль, отечность, покраснение. Постепенно токсины разносятся по кровеносной системе, и появляются общие симптомы стрептококковой инфекции. Любое заболевание, вызванное этим микроорганизмом, будет сопровождаться слабостью, общим недомоганием, тошнотой. В тяжелых случаях может развиваться обезвоживание и нарушения сознания.
Эта бактерия является чужеродной, потому иммунитет начинает вырабатывать антитела, реагируя на стрептококк, как на сильнейший аллерген. В этом есть существенный минус, ведь такое реагирование может привести к аутоиммунным заболеваниям. Это грозит такими осложнениями, как ревматоидный артрит, эндокардит, миокардит, перикардит.
Передается стрептококк контактным, пищевым, половым и воздушно-капельным путем. Есть факторы, которые могут значительно повлиять на вероятность развития стрептококковой инфекции.
К таким факторам относятся:
- эндокринные заболевания;
- ВИЧ, аутоиммунная патология;
- ОРВИ, анаэробные и вирусные инфекции;
- хронические патологии желудочно-кишечного тракта;
- язва двенадцатиперстной кишки, гастрит желудка.
Наиболее частые заболевания у взрослых, вызванные стрептококком, это тонзиллит, фарингит, ангина. К более серьезным патологиям можно отнести отит, воспаление легких, дерматит. Рассмотрим подробнее самые распространенные стрептококковые инфекции.
Гемолитический стрептококк, особенно группы A, вызывает интерес у специалистов в области урологии. Многие пациенты не осознают, что этот микроорганизм может быть причиной различных инфекций мочевыводящих путей. Врачи отмечают, что стрептококковая инфекция может проявляться в виде цистита, уретрита и даже пиелонефрита. Симптомы часто схожи с другими инфекциями, что затрудняет диагностику. Люди делятся опытом, рассказывая о затяжных курсах лечения и необходимости комплексного подхода, включая антибиотикотерапию и поддерживающую терапию. Важно отметить, что своевременное обращение к врачу и правильная диагностика играют ключевую роль в успешном лечении. Обсуждения на форумах показывают, что пациенты ищут информацию о профилактике и последствиях, что подчеркивает необходимость повышения осведомленности о данной проблеме.
Фарингит
Это заболевание начинается остро, проявляется специфическими выраженными симптомами.
Основные признаки фарингита:
- сильная боль во время глотания;
- повышение температуры тела до 38 градусов;
- расстройство пищеварения;
- увеличение и болезненность лимфатических узлов;
- изменение голоса;
- сухой кашель;
- общее недомогание.
Это заболевание быстро диагностируется по таким признакам, как отечность слизистой глотки, покраснение и серый налет. Это заболевание всегда сопровождается насморком с обильным выделением слизи. Больному в обязательном порядке назначаются местные антисептики для полоскания горла. Лечение антибиотиками для внутреннего приема в данном случае не применяется. В группу риска попадают молодые и пожилые люди с ослабленным иммунитетом, которые контактируют с бактерионосителем.

Вопрос-ответ
Какие болезни вызывает гемолитический стрептококк?
Попадая в кровь, стрептококк распространяется по другим органам и тканям и вызывает средний отит, синусит, паратонзиллярный абсцесс, пневмонию, эндокардит, послеродовый сепсис, септицемию (заражение крови). Возможно развитие стрептококкового токсического шока и некротизирующего фасциита.

Каковы симптомы стрептококковой инфекции мочеполовой системы?
У мужчин признаками поражения мочеполовой системы стрептококковой инфекцией могут быть зуд, жжение, болезненность во время мочеиспускания, слизисто-гнойные выделения из уретры. У женщин стрептококки могут вызывать такие инфекционные патологии, как вагинальный стафилококк, хламидиоз, трихомониаз.
Что вызывает появление стрептококка группы В в моче?
Несмотря на высокую распространенность GBS в уретре, особенно у лиц с заболеваниями, передающимися половым путем (ЗППП), это редкая причина ИМП [4, 5]. GBS в основном связан с послеродовой инфекцией, которая возникает в результате вертикальной передачи бактерий из-за материнской цервико-вагинальной колонизации .
Можно ли заразиться стрептококком при половом акте?
Стрептококки группы B являются частью нормальной микрофлоры влагалища и не являются заболеванием, передающимся половым путем.
Советы
СОВЕТ №1
Обратите внимание на симптомы: если вы заметили признаки инфекции, такие как болезненное мочеиспускание, частые позывы к мочеиспусканию или изменение цвета мочи, не откладывайте визит к врачу. Раннее обращение за медицинской помощью может предотвратить осложнения.
СОВЕТ №2
Следите за личной гигиеной: регулярное соблюдение правил личной гигиены может помочь снизить риск заражения гемолитическим стрептококком. Убедитесь, что вы моете руки перед и после туалета, а также используете чистое нижнее белье.
СОВЕТ №3
Обсудите с врачом возможные профилактические меры: если у вас есть предрасположенность к инфекциям мочевыводящих путей, обсудите с врачом возможные способы профилактики, такие как изменение диеты или использование пробиотиков.
СОВЕТ №4
Не занимайтесь самолечением: при подозрении на инфекцию не пытайтесь лечиться самостоятельно. Обратитесь к специалисту для получения точного диагноза и назначения адекватного лечения, так как неправильное лечение может усугубить ситуацию.